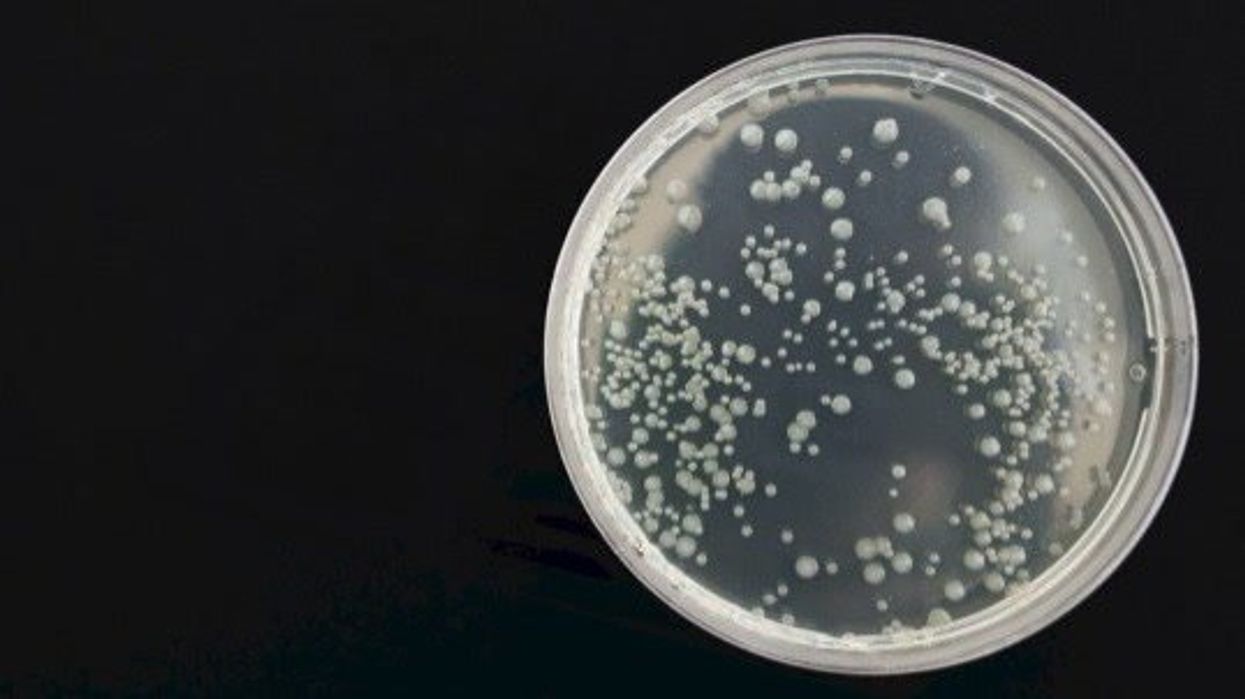
Mysterious 'mirror life' bacteria could take out everything on Earth, scientists warn

Science & Tech
Liam O'Dell
Dec 15, 2024
Related video: Bacteria can sometimes change its shape in order to survive
ZMG - Amaze Lab / VideoElephant
Molecules which are the building blocks of life can be either “right-handed” or “left-handed” in terms of their structure – with DNA coming from “right-handed” nucleotides and proteins originating from “left-handed” amino acids – but this principle underpins a kind of science which is worrying academics.
An international group of 38 scientists – including academics from Stanford, Yale, the Massachusetts Institute of Technology (MIT) in the US; and the University of East Anglia and the University of Cambridge in the UK – issued a warning in an article published in the journal Science on Thursday.
Their concern surrounds what’s known as “mirror life” – that is, the creation of synthetic lifeforms from “mirror-image biological molecules”.
They say the capability to create such life is “likely at least a decade away”, but note progress on “key enabling technologies” is very much “underway”, with scientists already building synthetic cells “of natural chirality” or asymmetry from non-living parts.
So, what’s the risk?
Well, the researchers’ analysis suggests mirror bacteria could very well evade our immune systems, as well as those of animals and plants; could be resistant to being consumed by predators; and could be resistant to “most antibiotics”.
Yikes.
“Much like an invasive species with few natural predators, we are concerned that mirror bacteria could rapidly proliferate, evolving and diversifying as they spread.
“Persistent and potentially global presence of mirror bacteria in the environment could repeatedly expose human, animal and plant populations to the risk of lethal infection,” they warn.
Outlining their recommendations, the academics write that mirror organisms “should not be created” – even with “biocontainment measures” – unless it emerges that there is “compelling evidence” that mirror life would not “pose extraordinary dangers”.
They continue: “We therefore recommend that research with the goal of creating mirror bacteria not be permitted, and that funders make clear that they will not support such work.
“We recommend that initially, steps be taken to prevent the production of mirror genomes and proteomes, or functional equivalents sufficient to enable the construction of a mirror cell.
“We also recommend research to better understand and prepare for risks from mirror bacteria, as long as neither mirror bacteria nor any key enabling precursors are produced. Such research might include studying the interaction of mirror biomolecules with the immune system as well as developing detection methods and biosurveillance systems.
“None of these research directions would require mirror bacteria to be built.”
Needless to say, the journal article has given the scientific community something to ‘reflect’ upon…
It comes after scientists from Spain and Japan discovered a whole host of bacteria and fungi in a layer of Earth's atmosphere known as the planetary boundary layer or troposphere – including E. coli and one particular organism commonly found in the most unusual of places.
Sign up to our free Indy100 weekly newsletter
How to join the indy100's free WhatsApp channel
Have your say in our news democracy. Click the upvote icon at the top of the page to help raise this article through the indy100 rankings.
Top 100
The Conversation (0)